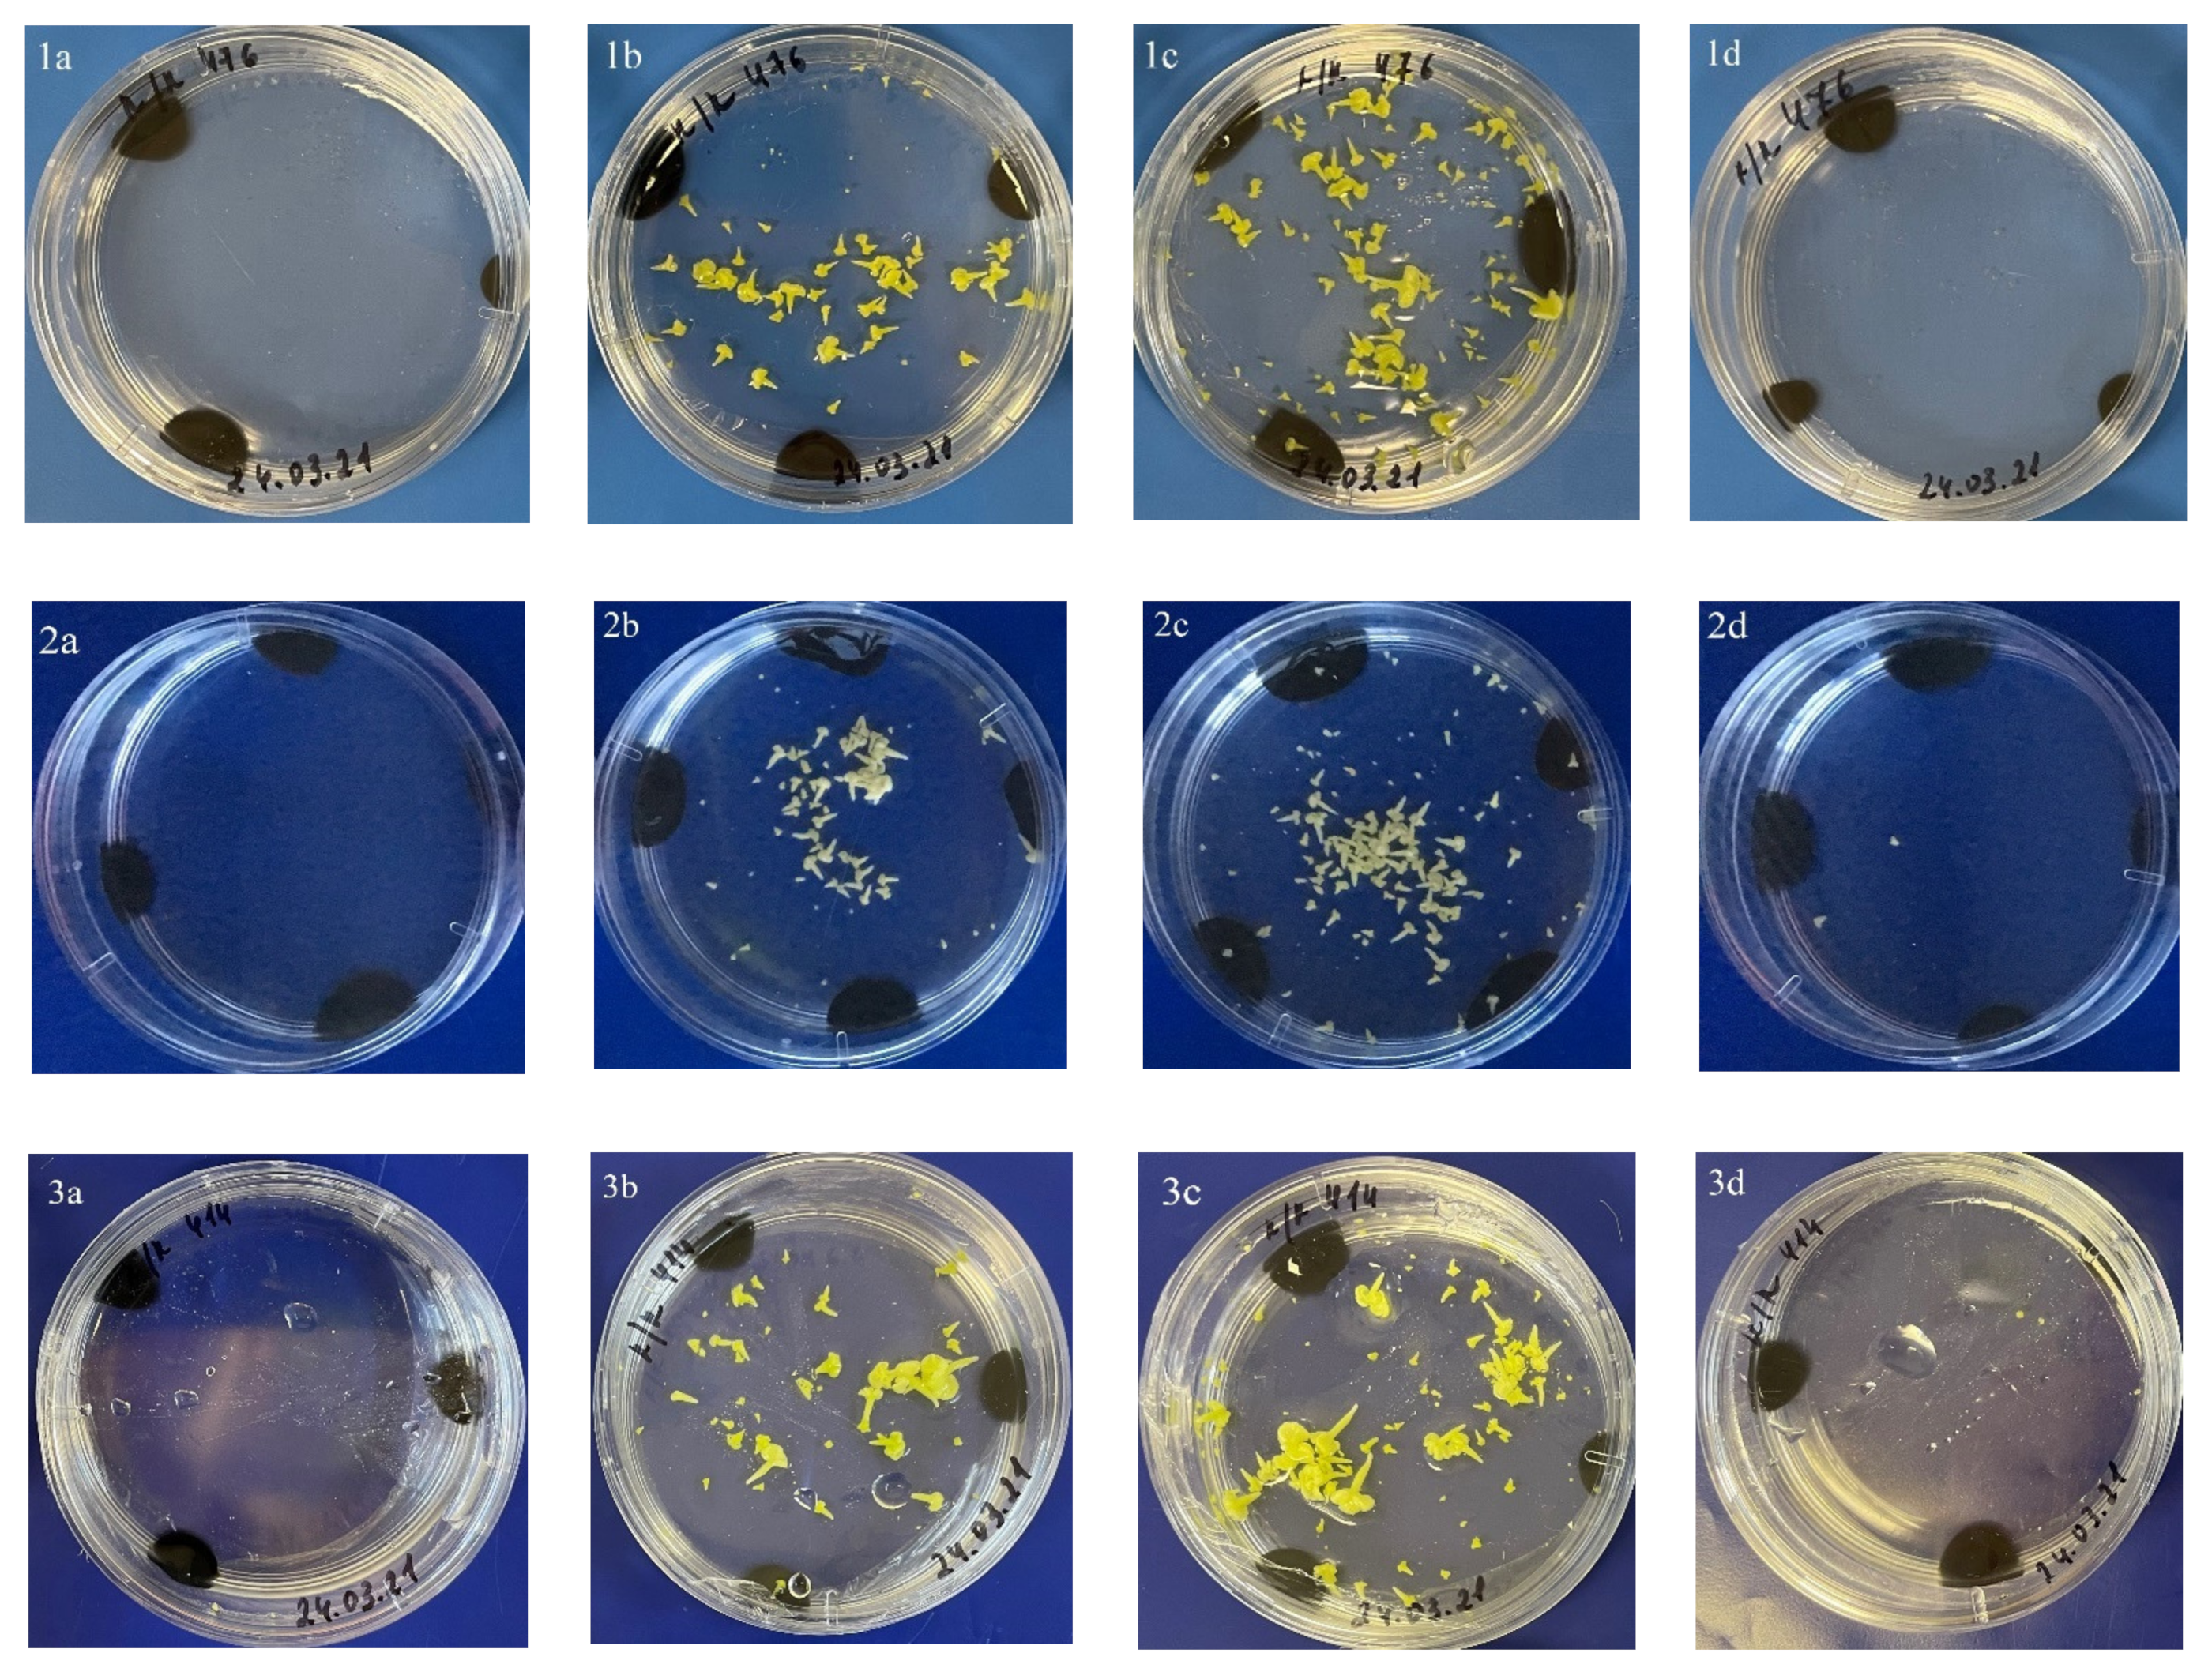
Plants 10 01950 g005

Androgenesis of Red Cabbage in Isolated Microspore Culture In Vitro
Abstract
1. Introduction
2. Results
2.1. Development of Red Cabbage Embryoids from Microspores in In Vitro Culture
2.2. Determination of the Dependence of the Yield of Embryoids on the Size of the Buds
2.3. Influence of Acidity of the Culture Medium on Embryoid Yield
2.4. Heat Shock Treatments
2.5. Plant Regeneration
2.6. Evaluation of the Regenerated Plants of Red Cabbage
3. Discussion
4. Materials and Methods
4.1. Plant Material and Plant Growing Conditions
4.2. Influence of Size of Buds on Embryoids Yield
4.3. Microspore Culture
4.4. Influence of Acidity of the Culture Medium on Embryoid Yield
4.5. Influence of the Duration of Heat Shock Treatment on Embryoid Yield
4.6. Plant Regeneration
4.7. Adaptation of Regenerated Plants to In Vivo Conditions
4.8. Ploidy Level Determination
4.9. Producing Seed Offspring of DH Plants
5. Conclusions
Author Contributions
Funding
Institutional Review Board Statement
Informed Consent Statement
Data Availability Statement
Acknowledgments
Conflicts of Interest
References
- Malakhova, E.I.; Temirbekova, S.K.; Kulikov, I.M.; Afanasyeva, Y.V. New varieties of cauliflower and headed cabbages. Veg. Crop. Russ. 2013, 2, 63–64. [Google Scholar] [CrossRef]
- Borisov, V.A.; Litvinov, S.S.; Romanova, A.V. Quality and Keeping Quality of Vegetables; CRC Press: Moscow, Russia, 2003; pp. 139–149. [Google Scholar]
- Singh, J.; Upadhyay, A.K.; Bahadur, A.; Singh, B.; Singh, K.P.; Rai, M. Antioxidant phytochemicals in cabbage (Brassica oleracea L. var. capitata). Sci. Hort. 2006, 108, 233–237. [Google Scholar] [CrossRef]
- Can, N.O.; Altiokka, G. Quantitative analysis of natural antioxidants pelargonidin and peonidin in fresh vegetables using an ODS-3 liquid chromatography column. Toxicol. Lett. 2007, 172, S225. [Google Scholar] [CrossRef]
- Abdel-Aal, E.-S.M.; Abou-Arab, A.A.; Gamel, T.H.; Hucl, P.; Young, J.C.; Rabalski, I. Fractionation of blue wheat anthocyanin compounds and their contribution to antioxidant properties. J. Agric. Food Chem. 2008, 56, 11171–11177. [Google Scholar] [CrossRef]
- Dunwell, J.M. Haploids in flowering plants: Origins and exploitation. Plant Biotechnol. J. 2010, 8, 377–424. [Google Scholar] [CrossRef]
- Lichter, R. Induction of haploid plants from isolated pollen of Brassica napus. Z. für Pflanzenphysiologie 1982, 105, 427–434. [Google Scholar] [CrossRef]
- Ferrie, A.M.R. Microspore culture of Brassica species. In Doubled Haploid Production in Crop Plants; Maluszynski, M., Ed.; Springer Science & Business Media: Dordrecht, The Netherlands, 2003; pp. 205–215. [Google Scholar]
- Smykalova, I.; Vetrovcova, M.; Klima, M.; Machackova, M.; Griga, M. Efficiency of Microspore Culture for Doubled Haploid Production in the Breeding Project “Czech Winter Rape”. Czech J. Genet. Plant Breed. 2006, 42, 58–71. [Google Scholar] [CrossRef]
- Reeta, B.; Dey, S.S.; Parkash, C.; Sharma, K.; Sood, S.; Kumar, R. Modification of important factors for efficient microspore embryogenesis and doubled haploid production in field grown white cabbage (Brassica oleracea var. capitata L.) genotypes in India. Sci. Hortic. 2018, 233, 178–187. [Google Scholar] [CrossRef]
- Shumilina, D.V.; Shmykova, N.A.; Bondareva, L.L.; Suprunova, T.P. Effect of genotype and medium culture content on microspore—derived embryo formation in chinese cabbage (Brassica rapa ssp. chinensis) cv. Lastochka. Biol. Bull. 2015, 42, 302–309. [Google Scholar] [CrossRef]
- Baidina, A.V.; Monakhos, G.F.; Monakhos, S.G. F1 Nastya—A new cabbage hybrid. Potato Veg. 2017, 11, 32–33. [Google Scholar]
- Domblides, E.A.; Kozar, E.V.; Shumilina, D.V.; Zayachkovskaya, T.V.; Akhramenko, V.A.; Soldatenko, A.V. Embryogenesis in cukture of isolated microspore of broccoli. Veg. Crop. Russ. 2018, 1, 3–7. [Google Scholar] [CrossRef]
- Zablotskaya, E.A.; Bondareva, L.L.; Sirota, S.M. Correlation links between some economically valuable signs in broccoli. Veg. crop. Russ. 2018, 1, 8–11. [Google Scholar] [CrossRef][Green Version]
- Domblides, E.A.; Chichvarina, O.A.; Mineykina, A.I.; Kurbakov, E.L.; Kharchenko, V.A.; Domblides, A.S.; Soldatenko, A.V. Rapid development of homozygous lines through culture of isolated microspores in leafy crops of Brassicaceae Burnett. Veg. Crop. Russ. 2019, 4, 8–12. [Google Scholar] [CrossRef]
- Kozar, E.V.; Korottseva, K.S.; Romanova, O.V.; Chichvarina, O.A.; Kan, L.Y.; Ahramenko, V.A.; Domblides, E.A. Production of doubled haplois in Brassica purpuraria. Veg. Crop. Russ. 2019, 6, 10–18. [Google Scholar] [CrossRef]
- Mineykina, A.I.; Bondareva, L.L.; Shumilina, D.V.; Domblides, E.A.; Soldatenko, A.V. Improvement of methods of creating hybrids of cabbage. Veg. Crop. Russ. 2019, 4, 3–7. [Google Scholar] [CrossRef]
- Kozar, E.V.; Domblides, E.A.; Soldatenko, A.V. Factors affecting DH plants in vitro production from microspores of European radish. Vavilov J. Genet. Breed. 2020, 24, 31–39. [Google Scholar] [CrossRef]
- Shumilina, D.; Kornyukhin, D.; Domblides, E.; Soldatenko, A.; Artemyeva, A. Impact of genotype and culture conditions on microspore embryogenesis and plant regeneration in Brassica Rapa ssp. Rapa L. Plants 2020, 9, 278. [Google Scholar] [CrossRef]
- Mineykina, A.; Shumilina, D.; Bondareva, L.; Soldatenko, A.; Domblides, E. Effect of beta-lactam antibiotics on microspore embryogenesis in Brassica Species. Plants 2020, 9, 489. [Google Scholar] [CrossRef]
- Pechan, P.M.; Keller, W.A. Identification of potentially embryogenic microspores in Brassica napus. Physiol. Plant 1988, 74, 377–384. [Google Scholar] [CrossRef]
- Bhowmik, P.; Dirpaul, J.; Polowick, P.; Ferrie, A.M.R. A high throughput Brassica napus microspore culture system: Influence of percoll gradient separation and bud selection on embryogenesis. Plant Cell Tissue Organ Cult. 2011, 106, 359–362. [Google Scholar] [CrossRef]
- Domblides, E.A.; Shmykova, N.A.; Shumilina, N.A.; Zayachkovskaya, T.V.; Mineykina, A.I.; Kozar, E.V.; Ahramenko, V.A.; Shevchenko, L.L.; Kan, L.J.; Bondareva, L.L.; et al. A Technology for Obtaining Doubled Haploids in Microspore Cultures of the Brassicaceae Family (Guidelines); VNIISSOK: Moscow, Russia, 2016; p. 40. [Google Scholar]
- Bajaj, Y.P.S.; Nietsch, P. In vitro Propagation of Red Cabbage (Brassica oleracea L. var. capitata). J. Exp. Bot. 1975, 26, 883–890. [Google Scholar] [CrossRef]
- Chen, L.-P.; Zhang, M.-F.; Xiao, Q.-B.; Wu, J.-G.; Hirata, Y. Plant Regeneration from Hypocotyl Protoplasts of Red Cabbage (Brassica Oleracea) by Using Nurse Cultures. Plant Cell Tissue Organ Cult. 2004, 77, 133–138. [Google Scholar] [CrossRef]
- Pavlovic, S.; Vinterhalter, B.; Mitic, N.; Adzic, S.; Pavlovic, N.; Zdravkovic, M.; Vinterhalter, D. In vitro shoot regeneration from seedling explants in Brassica vegetables: Red cabbage, broccoli, Savoy cabbage and cauliflower. Arch. Biol. Sci. 2010, 62, 337–345. [Google Scholar] [CrossRef]
- Al-Hardan, G.M.; Al-Shamari, M.; Ali Hanshil, M. Impact of culture medium and 2,4-D on direct somatic embryogenesis in red cabbage (Brassica oleracea var.capitata forma rubra). Plant Arch. 2020, 20, 3022–3026. [Google Scholar]
- Cilingir, A.; Dogru, S.M.; Kurtar, E.S.; Balkaya, A. Anther Culture in Red Cabbage (Brassica oleraceae L. var.capitata subvar. rubra): Embryogenesis and Plantlet Initiation. Ekin. J. 2017, 3, 82–87. [Google Scholar]
- Vyvadilova, M.; Klima, M.; Kucera, V. Embryogenic responsibility of Brassica oleracea vegetables in a microspore culture. Hortic. Sci. 2001, 28, 121–124. [Google Scholar]
- Baillie, A.M.R.; Epp, D.J.; Hutcheson, D.; Keller, W.A. In vitro culture of isolated microspores and regeneration of plants in Brassica campestris. Plant Cell. Rep. 1992, 11, 234–237. [Google Scholar] [CrossRef]
- Simmonds, D.H.; Keller, W.A. Significance of pre-prophase bands of microtubules in the induction of microspore embryogenesis of Brassica napus. Planta 1999, 208, 383–391. [Google Scholar] [CrossRef]
- Ferrie, A.M.R.; Caswell, K.L. Isolated microspore culture techniques and recent progress for haploid and doubled haploid plant production. Plant Cell Tissue Organ Cult. 2010, 104, 301–309. [Google Scholar] [CrossRef]
- Shmykova, N.A.; Shumilina, D.V.; Suprunova, T.P. Doubled haploid production in Brassica L. seeds. Vavilov J. Genet. Breed. 2015, 19, 111–120. [Google Scholar] [CrossRef][Green Version]
- Huang, B.; Bird, S.; Kemble, R.; Simmonds, D.; Keller, W.; Miki, B. Effects of culture density, conditioned medium feeder cultures on microspore embryogenesis in Brassica napus L. cv. Topas. Plant Cell Rep. 1990, 8, 594–597. [Google Scholar] [CrossRef]
- Arnison, P.G.; Donaldson, P.; Ho, L.C.C.; Keller, W.A. The influence of various physical parameters on anther culture of broccoli (Brassica oleracea var.italica). Plant Cell Tissue Organ Cult. 1990, 20, 147–155. [Google Scholar] [CrossRef]
- Butenko, R.G. Cell Biology of Higher Plants In Vitro and Biotechnology Based on Them; VNIISSOK: Moscow, Russia, 1999; p. 160. [Google Scholar]
- Bunin, M.S.; Shmykova, N.A.; Stepanov, V.I.; Startsev, V.I.; Bondareva, L.L. Methods of Reproductive Biology in the Breeding of Vegetable Crops of the Brassica L; VNIISSOK: Moscow, Russia, 2003; pp. 37–39. [Google Scholar]
- Yuan, S.; Su, Y.; Liu, Y.; Fang, Z.; Yang, L.; Zhuang, M.; Zhang, Y.; Sun, P. Effects of pH, MES, arabinogalactan-proteins on microspore cultures in white cabbage. Plant Cell Tissue Organ Cult. 2012, 110, 69–76. [Google Scholar] [CrossRef]
- Barinova, I.; Clement, C.; Martiny, L.; Baillieul, F.; Soukupova, H.; Heberle-Bors, E.; Touraev, A. Regulation of developmental pathways in cultured microspores of tobacco and snapdragon by medium pH. Planta 2004, 219, 141–146. [Google Scholar] [CrossRef] [PubMed]
- Telmer, C.A.; Simmonds, D.; Newcomb, W. Determination of developmental stage to obtain high frequencies of embryogenic microspores in Brassica napus. Physiol. Plant 1992, 84, 417–424. [Google Scholar] [CrossRef]
- Su, H.; Chen, G.; Yang, L.; Zhang, Y.; Wang, Y.; Fang, Z.; Lv, H. Proteomic variations after short-term heat shock treatment reveal differentially expressed proteins involved in early microspore embryogenesis in cabbage (Brassica oleracea). PeerJ 2020, 8, e8897. [Google Scholar] [CrossRef]
- Takahata, Y.; Keller, W.A. High frequency embryogenesis and plant regeneration in isolated microspore culture of Brassica oleracea L. Plant Sci. 1991, 74, 235–242. [Google Scholar] [CrossRef]
- Pang, E.C.K. Production of Doubled Haploid Plants in Brassica Oleracea; Horticultural Australia Ltd.: Sydney, Australia, 2004; p. 52. [Google Scholar]
- Romeijn, G.; Lammeren, A.A.M. Plant regeneration through callus initiation from anthers and ovules of Scabiosa columbaria. Plant Cell Tissue Organ Cult. 1999, 56, 169–177. [Google Scholar] [CrossRef]
- Kaltchuk-Santos, E.; Mariath, J.E.; Mundstock, E.; Hu, C.Y.; Bodanese-Zanettini, M.H. Cytological analysis of early microspore divisions and embryo formation in cultured soybean anthers. Plant Cell Tissue Organ Cult. 1997, 49, 107–115. [Google Scholar] [CrossRef]
- Huang, B.; Bird, S.; Kemble, R.; Miki, B.; Keller, W. Plant regeneration from microspore-derived embryos of Brassica napus: Effect of embryo age, culture temperature, osmotic pressure, and abscisic acid. Vitr. Cell Dev. Biol. 1991, 27, 28–31. [Google Scholar] [CrossRef]
- Cegielaka-Taras, T.; Tykarska, T.; Szala, L.; Kuras, M.; Krzymanski, J. Direct plant regeneration from microspore derived embryos of winter oilseed rape Brassica napus L. ssp. oleifera (DC.) Metzger. Euphytica 2002, 124, 341–347. [Google Scholar] [CrossRef]
- Haddadi, P.; Moieni, A.; Karimzadeh, G.; Abdollahi, M.R. Effects of gibberellin, abscisic acid and embryo desiccation on normal plantlet regeneration, secondary embryogenesis and callogenesis in microspore culture of Brassica napus L. cv. PF 704. Int. J. Plant Prod. 2008, 2, 153–162. [Google Scholar]
- Hadfi, K.; Speth, V.; Neuhaus, G. Auxin-induced developmental patterns in Brassica juncea embryos. Development 1998, 125, 879–887. [Google Scholar] [CrossRef]
- Hamaoka, Y.; Fujita, Y.; Iwai, S. Nimber of Chloroplasts in Haploids and Diploids Produced via Anther Culture in Brassica campestris. Plant Tissue Cult. Lett. 1991, 8, 67–72. [Google Scholar] [CrossRef][Green Version]
- Murovec, J.; Bohanec, B. Haploids and Doubled Haploids in Plant Breeding. Plant Breed. 2012, 87–106. [Google Scholar] [CrossRef]
- Ockendon, D.J. The ploidy of plants obtained from anther culture of caulifrowers (Brassica oleracea var. botrytis). Ann. Appl. Biol. 1988, 113, 319–325. [Google Scholar] [CrossRef]
- Chen, J.L.; Beversdorf, W.D. Production of spontaneous diploid lines from isolated microspores following cryopreservation in spring rapeseed (Brassica napus L.). Plant Breed. 1992, 108, 324–327. [Google Scholar] [CrossRef]
- Farnham, M.W. Doubled-haploid broccoli production using anther culture: Effect of anther source and seed set characteristics of derived lines. J. Am. Soc. Hortic. Sci. 1998, 123, 73–77. [Google Scholar] [CrossRef]
- Zablotskaya, E.A.; Mineykina, A.I.; Domblides, E.A.; Paslova, T.O.; Bondareva, L.L. Broccoli various genotypes regenerated plants (R0) seed set after geitonogamy. Veg. Crop. Russ. 2020, 2, 43–46. [Google Scholar] [CrossRef]
- Alexander, M.P. Differential staining of aborted and non-aborted pollen. Stain Technol. 1969, 44, 117–122. [Google Scholar] [CrossRef]
- Shumilina, D.; Kozar, E.; Chichvarina, O.; Korottseva, K.; Domblides, E. Brassica rapa L. ssp. chinensis Isolated microspore culture protocol. In Doubled Haploid Technology; Jose, M.S.-S., Ed.; Springer Science+Business Media: Valencia, Spain, 2021; Volume 2, pp. 145–162. [Google Scholar] [CrossRef]
- Kozar, E.; Domblides, E. Protocol of European radish (Raphanus sativus L.) Microspore culture for doubled haploid plant production. In Doubled Haploid Technology; Jose, M.S.-S., Ed.; Springer Science+Business Media: Valencia, Spain, 2021; Volume 2, pp. 217–232. [Google Scholar] [CrossRef]
- Murashige, T.; Skoog, F. Revised medium for rapid growth and bioassays with tobacco tissue. Physiol. Plant 1962, 15, 473–497. [Google Scholar] [CrossRef]
- Skaptsov, M.V.; Smirnov, S.V.; Kutsev, M.G.; Shmakov, A.I. Problems of a standardization in plant flow cytometry. Turczaninowia 2016, 19, 3, 120–122. [Google Scholar]
- Bunin, M.S.; Monachos, G.F.; Terekhova, V.I. Production of Hybrid Vegetable Seeds; RSAU-Moscow Agricultural Academy named after K.A. Timiryazeva: Moscow, Russia, 2011; p. 182. [Google Scholar]

| Genotype | Bud Length, mm | |||
|---|---|---|---|---|
| 3.7–4.0 | 4.1–4.4 | 4.5–5.0 | 5.1–5.7 | |
| cv. Kamennaya golovka | 1.0 ± 1.5 a | 23.0 ± 4.0 d | 4.5 ± 3.5 ab | 0 a |
| b.a. 428 | 8.5 ± 1.5 b | 14.0 ± 2.0 c | 0 a | 0 a |
| b.a. 1 | 0 a | 11.5 ± 0.5 c | 21.5 ± 1.5 d | 0 a |
| cv. Gako | 0 a | 64.0 ± 6.0 e | 131.5 ± 16.5 h | 0 a |
| F1 Red Jewel | 0 a | 82.5 ± 3.5 f | 4.5 ± 0.5 b | 0 a |
| b.a. 7-3 | 0 a | 96.7 ± 4.3 g | 79.0 ± 3.2 f | 1.7 ± 0.7 a |
| Accession | No. of Plants | Ploidy Level | |||||
|---|---|---|---|---|---|---|---|
| Diploid | Aneuploid | Tetraploid | |||||
| No. | % | No. | % | No. | % | ||
| b.a. 428 | 4 | 4 | 100 | 0.0 | 0.0 | 0 | 0.0 |
| b.a. 1 | 8 | 8 | 100 | 0.0 | 0.0 | 0 | 0.0 |
| cv. Gako | 30 | 25 | 83.3 | 2 | 6.7 | 3 | 10.0 |
| F1 Red Jewel | 16 | 16 | 100 | 0 | 0.0 | 0 | 0.0 |
| b.a. 7-3 | 30 | 27 | 90.0 | 1 | 3.3 | 2 | 6.7 |
| Total | 88 | 80 | 3 | 5 | |||
| Mean, % | 90.9 | 3.4 | 5.7 | ||||
Publisher’s Note: MDPI stays neutral with regard to jurisdictional claims in published maps and institutional affiliations. |
© 2021 by the authors. Licensee MDPI, Basel, Switzerland. This article is an open access article distributed under the terms and conditions of the Creative Commons Attribution (CC BY) license (https://creativecommons.org/licenses/by/4.0/).
Share and Cite
Mineykina, A.; Bondareva, L.; Soldatenko, A.; Domblides, E. Androgenesis of Red Cabbage in Isolated Microspore Culture In Vitro. Plants 2021, 10, 1950. https://doi.org/10.3390/plants10091950
Mineykina A, Bondareva L, Soldatenko A, Domblides E. Androgenesis of Red Cabbage in Isolated Microspore Culture In Vitro. Plants. 2021; 10(9):1950. https://doi.org/10.3390/plants10091950
Chicago/Turabian StyleMineykina, Anna, Ludmila Bondareva, Alexey Soldatenko, and Elena Domblides. 2021. "Androgenesis of Red Cabbage in Isolated Microspore Culture In Vitro" Plants 10, no. 9: 1950. https://doi.org/10.3390/plants10091950
APA StyleMineykina, A., Bondareva, L., Soldatenko, A., & Domblides, E. (2021). Androgenesis of Red Cabbage in Isolated Microspore Culture In Vitro. Plants, 10(9), 1950. https://doi.org/10.3390/plants10091950

